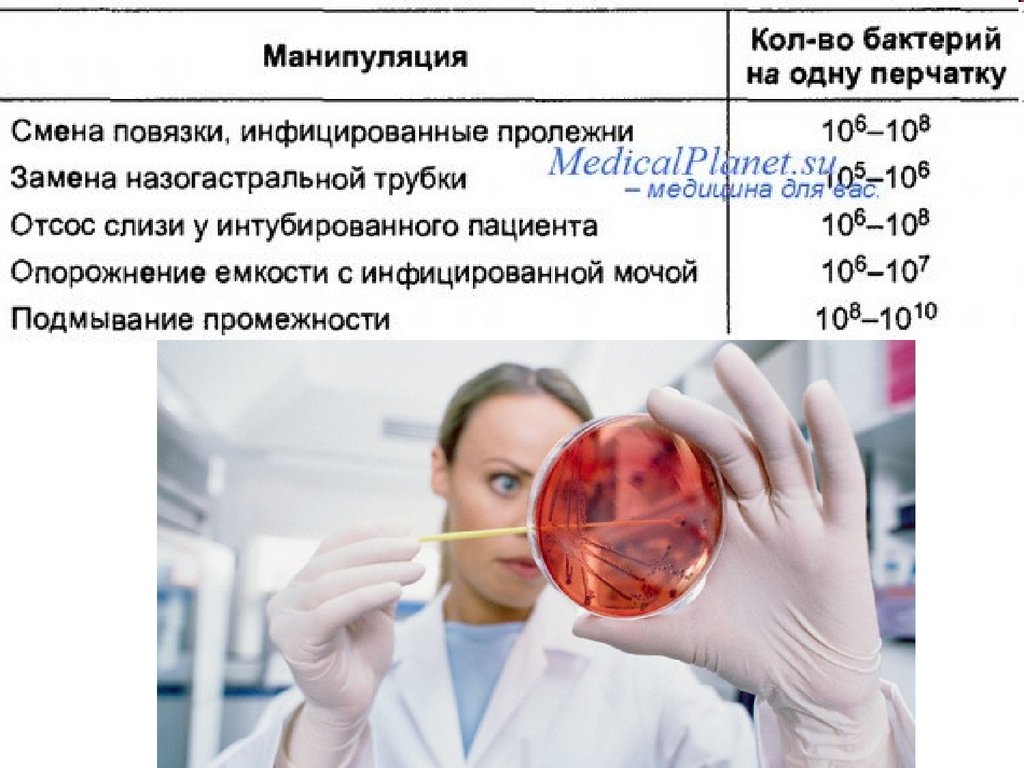

Похожие презентации:
1.Асептика,антисептика
1.
Историческаясправка
2.
Проведение операции в средние века3.
Развитие хирургии I периодДревний Египет: ампутации конечностей, трепанация
черепа, в гробницах первые инструменты
Древняя Индия: замещение дефекта носа кожным
лоскутом на ножке, трепанация, остановка
кровотечения прижиганием кипящим маслом.
Использование для обезболивания опия, сока конопли
и др.
Древняя Греция: основоположник медицины
Гиппократ предлагает способы лечения ран, описывает
столбняк и сепсис. проводит торакотомию, изложил
способы лечения переломов и вывихов и др.
4.
Развитие хирургии I периодСредние века: выдающийся врач Абу-Али-Ибн-Сина дренирование ран, рекомендовал специальные разрезы,
применение тампонов и дренажей и др.
Париж 829 г. открыто первое лечебное учреждение с
хирургическими койками
Появляются первые университеты в Болонье (1158г.) Кембридже
(1209г.), Падуе (1222г.), позднее в Праге, Вене, Кёльне
Киевская Русь лечится у монахов, лекарей, костоправов,
травников, лечцов. С XI в. русскими лечцами производились:
лечились язвы, переломы, развивались десмургия и др.
До 19 в. 75% больных умирали от гнойных осложнений и
кровотечений
Амбруаз Паре: предложил перевязывать сосуды в ране
1750г. указом короля Франции хирурги признаны врачами с
правом самостоятельной практики. В Париже Королевской
академии хирургии
5.
Развитие хирургии I периодРоссия 1707г. при Московском генеральном госпитале
были учреждены анатомический театр и госпитальная
школа для подготовки хирургов
1755г. Москва первый русский университет с
медицинским факультетом и клиниками. С 1786г.
госпитальные школы
преобразовывают в медикохирургические училища.
В 1798г. основаны Московская и Петербургская медико хирургические академии.
Известными хирургами - учеными того времени были
И.В. Буяльский, И.Ф. Буш, Х.Х. Саломон, П.Н. Савенко и
др.
Европейские хирургии: Ж. Лисфранка, Б. Лангенбека,
Ф.Эсмарха, Т.Бильрот, Э.Купер
6.
Проведение хирургической операции в 19 веке7.
Развитие хирургии II периодВ 1847г. Земмельвейс написал работу о причинах «горячки
родильниц»
Л. Пастер доказал, что причиной брожения и гниения являются
микробы
В 1867г. Листер, основываясь на работах Пастера предположил,
что причина нагноения ран - микробы
Листер ввёл метод борьбы с инфекцией, который был назван
антисептическим
Метод Листера позволил снизить летальность у операционных
больных в несколько раз
Н.И. Пирогов предположил, что причина нагноения ран - живые
организмы («миазмы»)
Этот период в России: Н.В. Склифосовский, А.А. Бобров, П.И.
Дьяков, Н.А. Вельяминов, С.П. Федоров, В.И. Разумовской и др.
8.
9.
Развитие хирургии III периодОткрытие группы крови и внедрение переливания крови
Разрабатываются методы искусственного кровообращения и
гипотермии
Появляется наркозно - дыхательная аппаратура.
Развиваются узкоспециализированные направления хирургии:
нейрохирургия, кардиохирургия, урология и др.
Открытие антибиотиков (А. Флеминг, 1929г. Англия)
С.С. Брюхоненко, С.С. Юдин, А.А. Вишневский, А.Н.
Бакулаев, П.А. Куприянов, Б.В. Петровский, Н.М. Амосов,
И.С. Колесников, Н.Н. Петров, В.Н. Шамов, П.А.Куприянов,
И.С. Жоров, Виноградов, Дьяченко В.А. Неговский
10.
Асептика11.
организм в целомЦель асептики: защита организма и
особенно операционной раны от
контакта с инфекцией
Всё, что соприкасается с раной,
должно быть стерильным
12.
13.
Основоположники асептики1878 год
Эрнст Бергман
Курт Шиммельбуш
14.
Эрнст Бергман ввёл в практику кипячениеПервый кипятильник
15.
Роберт Кох (1881 г.) и Э. Эсмарх предложили методстерилизации текучим паром.
В то же время в России Л. Л. Гейденрейх впервые доказал
эффективность стерилизации паром под повышенным
давлением, и в 1884 г. предложил использовать для
стерилизации автоклав.
Первые паровые автоклавы
16.
Его ученик Курт Шиммельбуш (нем.) создал в 1892 годбикс - коробку, до сих пор использующейся для
стерилизации - бикс Шиммельбуша.
Биксы старого образца
имеют на корпусе
окошки, которые
металлической
подвижной лентой могут
закрываться и
открываться.
Срок годности — 72 часа
Биксы нового образца имеют в крышке и на дне корпуса
антибактериальный фильтр. Срок годности — 20 дней
17.
Хирургическая инфекция вызывается:30 видами аэробных и анаэробных бактерий
9 видами грибов
8 видами вирусов
Чаще инфекцию вызывают:
стафилококки, стрептококки, протей,
синегнойная и кишечная палочки
18.
Входными воротами является любоенарушение целостности кожных покровов
и слизистых оболочек
В течение 6-8 часов после попадания в
организм микроб либо погибает,
погибает либо
начинает активно размножаться
(интактен) 3-5 дней, в дальнейшем вызывая
воспалительный процесс
Развитие заболевания зависит:
От общего состояния организма
Входных ворот (наличия питательная среда,
наличие или отсутствие кислорода)
Ответной реакции организма (иммунитета)
19.
Пути проникновения инфекциив рану:
экзогенный
воздушный
капельный
контактный
имплантационны
й
эндогенный
гематогенный
лимфогенный
контактный
20.
21.
Устройство оперблока:изолированное расположение оперблока
вход в оперблок через санпропускник
разделение на чистые и гнойные операционные
зональность операционной: стерильная зона - операционная
и стерилизационная, зона строгого режима предоперационная, моечная, зона ограниченного режима
материальная
приточно-вытяжное устройство вентиляции, в
операционных: 10 - 20 кратный воздухообмен в час, 50%
влажность, температура 22 -25° С, существуют
кондиционеры с подогревом стерильного воздуха.
ограничение посещений операционной и передвижения по ней
стены гладкие, кафельные; пол - плиточный, стыки стен
закруглены;
запрещение разговоров, ношение спецодежды и масок;
защита от статического электричества
бакконтроль персонала
22.
23.
24.
Воздушный путь (воздух, пыль):полы, потолки, стены должны быть из материала,
которые выдерживают многократную обработку
антисептическими растворами
регулярное проветривание, вентиляция, сокращение
контакта с воздухом
приточно-вытяжная система вентиляции
влажная уборка антисептиками (предварительная,
текущая, заключительная, генеральная)
ношение спецодежды и масок
соблюдение правил личной гигиены
ограничение хождения и разговоров
облучение УФО, применение бактерицидных ламп
25.
26.
27.
Капельный путь (слюна, гной, жидкости):использование масок и защитных очков
разговоры только по необходимости
не работать при воспалении и носительстве
возбудителя в носоглотке
не чихать и не кашлять в рану
текущая уборка
28.
Профилактика экзогенной инфекцииКонтактный путь:
дезинфекция
стерилизация инструментов, материала, белья,
жидкостей
хирургическая дезинфекция рук
обработка операционного поля
работать инструментами и в перчатках аподактильно!
Всё, что соприкасается с
раной – должно быть
стерильно!!!
29.
Поверхность кожи человека,слущивающийся эпидермис
30.
31.
Способобработки
Мытьё рук
Цель обработки (степень
деконтеминации)
Удаление грязи и транзиторной флоры,
контаминирующей кожу рук медицинского
персонала в результате контакта с
инфицированными или
колонизированными пациентами и/или
контаминированными объектами
окружающей среды
Гигиеническая
антисептика
Удаление или уничтожение транзиторной
микрофлоры
Хирургическая
антисептика
Удаление или уничтожение транзиторной
микрофлоры и снижение численности
резидентной (постоянной, нормальной)
флоры
Абсолютно стерильной кожа рук быть не может, поэтому
называем «хирургической дезинфекцией».
32.
33.
34.
35.
Обработка рук на операцию36.
37.
38.
организма):строгое соблюдение стерильности при
использовании:
шовного материала
эндопротезов
катетеров, дренажей, тампонов
металлоконструкций
трансплантируемых органов
39.
Профилактика эндогеннойинфекции
1. Лимфогенный – по лимфатическим сосудам
2. Гематогенный – по кровеносным сосудам
тщательное обследование и санация
повысить защитные силы организма
применение сульфаниламидов и антибиотиков
3. Контактная инфекция (из органов и
тканей, поражённых инфекцией)
своевременное удаление гнойных очагов
не допускать перфорации (прорыва)
40.
Организационные мероприятия:СанПиН 3.3686-21 «Санитарно-эпидемиологические
требования по профилактике инфекционных болезней» от
18.02.2021 Раздел ХХХII Профилактика инфекций,
связанных с оказанием медицинской помощи
Разделение на «чистую» и «гнойную»
Соблюдение санэпидрежима
Расположение операционных блоков
Обследование медработников
Специальная форма одежды
Правила уборки оперблока и перевязочной
Режим асептики складывается из трёх
составляющих:
Дезинфекция
Предстерилизационная обработка
Стерилизация
41.
Дезинфекция - метод, который обеспечиваетгибель вегетативных форм микроорганизмов,
многих вирусов, грибов, простейших
Химическая дезинфекция
чаще используется:
Физическая дезинфекция
кипячение - 30мин
0,03% раствор аналита на 30 мин в 2% соде - 15мин
0,05% раствор аналита на 15 мин в автоклаве -110° С 0,5 атм. 20мин
3% раствор хлорамина на 60 мин воздушный стерилизатор 120°С
45мин
6% раствор перекиси водорода +
Обжиг используется для большой
0.5% раствор СМС 60 мин
эмалированной посуды и
проводится обжигание открытым
пламенем в лаборатории (петли
для забора материала). Можно
применять в домашних условиях
при невозможности использования
других
42.
Предстерилизационная обработка:по мере использования – в накопитель (просто вода, моющий
раствор, дезрастворы – кроме 3% раствора хлорамина)
затем поместить в дезраствор (можно использовать
физическую дезинфекцию)
промыть под слегка тёплой проточной водой от крови, гноя,
дезинфенктантов щёткой или ёршиком 0,5 - 1мин.
поместить в моющий комплекс при температуре 50 - 55° С на
15 – 20 мин, здесь промыть щёткой или ёршиком каждое
изделие.
промыть под проточной водой 3 – 10 мин
ополоснуть в дистиллированной воде (5 мин), лучше
прокипятить 5 минут
высушить в сухожаровом шкафу при температуре 80 - 85° С
10 - 15 мин с приоткрытой дверью; аппаратом «фен»; на
полотенце
Выборочно провести пробы качества предстерилизационной
подготовки
43.
Дезраствор:3% раствор хлорамина – на 60 мин
пресепт (2таблетки на 5л воды) - 90 мин
0,5% спиртовой раствор хлоргексидин - 15мин
6% перекись водорода - 60мин
2% сайдекс - 15мин
0,03% нейтрального анолита – на 30 мин
0,05% нейтрального анолита – на 15 мин
2,4% раствор первомура – С 4 – на 15 мин
70% этиловый спирт – 30 мин
гипохлорид кальция 1,5% на 1 час
44.
Моющий комплекс:– 0,5% раствор: 5 грамм любого порошка
(кроме "Биолот") + 17 мл 33% раствора
пергидроля + вода до 1000мл
– 2% раствор питьевой соды – бикарбоната
натрия
– 0,5% раствор порошка "Биолот" при
температуре 40 - 45° С
Инструменты после гнойных операций, операций у больных,
перенесших в течение 5 последних лет гепатит, а также
при риске СПИДа обрабатываются отдельно от других
45.
Контроль качествапредстерилизационной подготовки
Азопирамовая проба
Амидопириновая
проба
Фенолфталеи
новая проба
реагирует на кровь,
лекарственные препараты,
хлорсодержащие препараты,
ржавчину, моющие средства
кровь, лекарственные
препараты,
хлорсодержащие
препараты
на моющие
средства
В равных количествах смешивают:
раствор азопирама + 3% раствор
перекиси водорода
5% спиртовой р-р
амидопирина+3%
перекиси водорода
1% спиртовой
раствор
фенолфталеина
Реакция:
на хлорсодержащие препараты и
ржавчину – буроватое окрашивание,
на остальное – фиолетовый с
переходом в сиреневый цвет
сине-зелёное
окрашивание
розовое
окрашивание
46.
Стерилизация – метод, которыйобеспечивает гибель вегетативных
и споровых форм микроорганизмов,
вирусов, грибов, простейших
Методы стерилизации:
I. Физические методы
II. Химические методы
47.
Физические методы:Воздействие высокой температурой:
горячим воздухом (сухожаровой шкаф,
сушильно-стерилизационные шкафы)
пар под давлением (автоклавирование)
кипячение (простое и дробное)
прокаливание, обжигание
Ультразвуком: инструменты
УФО: воздух, раны
Ионизирующим излучением: гамма-лучи,
лучи
рентген - лучи
Фильтрация: воздух, жидкости
48.
Сушильно-стерилизационный шкафT = 180° С 60 минут
T = 160° С 150минут
Инструменты использовать в
течение одной рабочей смены
−все виды инструментов
−стеклянная посуда
−эмалированная посуда
−многоразовые шприцы с
пометкой 200° С
−нельзя ткани и резину
49.
Сушильно – стерилизационный шкаф50.
Автоклавирование – пар поддавлением
Режим
Давлен
ие
Темпе
ратура
Основной2
0 мин.
2 атм.
132° С Операционное бельё
Перевязочный материал
Корозийностойкие
инструменты
Стеклянная посуда
Эмалированная посуда
Все шприцы многоразовые
Щадящий4 1,1атм.
5мин.
Предметы
стерилизации
120° С Резиновые изделия,
перчатки, многие
виды полимерных
изделий
51.
Современные форвакуумные автоклавыРежимы:
121 ⁰С от 20 до 25 мин
126 ⁰С от 12 до 15 мин
134 ⁰С от 5 до 7 мин ( зависит от
вида изделий и упаковки)
принудительно удаляют воздух
из камеры с последующей
стерилизационной
сушкой изделий
52.
Низкотемпературныйплазменный стерилизатор
В результате воздействия
электромагнитного излучения на
пероскид водород, образуется
плазма пероксида водорода из
свободных радикалов ОН-, Н+,
ООН- и видимого
ультрафиолетового излучения.
Создаётся биоцидная среда.
Биоцидная среда уничтожает всё
живое. Время стерилизации от
54 до 72 минут. Температура –
46±4⁰С. После отключения
электромагнита, образуются
молекулы воды и кислорода
“Sterrad” 100S
53.
стерилизаторСинтезирует озон из воздуха
Стерилизация при t 40⁰С
Экологически чистая
Безопасная
Без паузы между циклами
Простота обслуживания
Низкое энергопотребление 120Вт
54.
Камера УФбактерицидная
Срок хранения
инструментов 7
суток.
Работа 8000 часов
55.
Ультрафиолетовая камера «Стандарт»Ультрафиолетовая камера УФК -3
56.
Химические методы:антисептические растворы:
6% H₂O₂
2% сайдекс
2,5% глютаровый альдегид
1% дезоксон
пары формалина:
формальдегид 40%
формалин 4%
газы: окись этилена
57.
Химическая обработка инструментовасептическими растворами
58.
Химическая обработка инструментовасептическими растворами
а) в растворы погружают оптику, полимеры,
резиновые изделия
H₂O₂ 6% t=18 - 20⁰С на 360 мин (6 часов)
t=50⁰С на 180 мин (3 часа)
Дезоксон-1 1% t=18-20⁰С на 45 мин
Сайдекс 2% на 4 - 20 часов
б) промыть инструменты, в ёмкости со
стерильной водой дважды по 5 мин
в) хранить изделия 3 суток в стерильной
пелёнке в стерильном биксе
59.
В чашку Петри закладывают 50 гр. формальдегидаВремя обработки 12 - 24 часа
Замена формальдегида не реже 1 раза в месяц
Оптические приборы
Резиновые изделия
Полимерные изделия
Редко:
корозийностойкие
инструменты, стеклянная,
эмалированная посуда
60.
Физический метод контроля стерильностиРежим
стерилизации
Индикатор
Цвет до
стерилизации
Цвет после
стерилизации
Автоклав
120° С 1,1 атм
45 мин
Бензойная кислота
Серый
Голубой
Спелая слива
132° С 2 атм
20 мин
Мочевина
Розовый
Спелая вишня
Сухожаровой шкаф
180° С
60 мин
Виннокаменная
кислота, янтарная
кислота, тиомочевина
160° С
150минут
Левомицетин
Белый
Зеленоватожёлтый
Основан на плавлении кристаллов веществ при воздействии
определённой температуры. Физические термоиндикаторы
запаяны в ампулы. Каждое вещество имеет свой исходный и
окончательный цвет
61.
Термовременные индикаторыФирма «ВИНАР»
ИС – 120, ИС – 132, ИС – 160, ИС – 180
•МедИС
•Стеритест
•Стериконт
• ИНТЕСТ
•Фарматест
•Сан ИС
•ВИНАР -6 класс
62.
Режимстерилизации
Термоиндик
аторная
лента
Цвет до
стерилизации
Цвет после
стерилизации
120° С 1,1 атм.
45 мин
ИС - 120
Белый
Светлокоричневый
132° С 2 атм.
20 мин
ИС – 132
Белый
Коричневый
180° С
60 мин
ИС - 180
белый
Тёмнокоричневый
Современный химический метод основан на изменении цвета
термоиндикаторной ленты при определённой температуре термовременные индикаторы, которые меняют свой цвет
63.
64.
стерильности1 кратно в месяц плановая проверка санэпидстанции (выборочно
отдельных участков эпидобстановки и воздуха ЛПУ)
1 раз в 7 дней старшая медсестра отделения проводит смывы со стен,
столов, инструментов, операционного белья и перевязочного материала и
т.д. и в баклаборатории проводят посевы с идентификацией
микроорганизмов
65.
Рецеркулятор «Дезар»66.
Для предупреждения инфицирования раны с кожипациента, проводят двухэтапную обработку:
до операции – санитарно-гигиеническая обработка кожи,
проводит постовая сестра при плановой операции и сестра
приёмного покоя – при срочной операции
Накануне вечером – гигиеническая ванна, душ, смена
белья при необходимости
Утром, в день операции – обработать
антисептиком, высушить, сухое бритьё
операционного поля, затем обработка 70% спиртом
на операционном столе
В операционной обработка по ФилончиковуГроссиху (4-5 кратная обработка)
67.
Обработка по Филончикову-ГроссихуШирокая обработка операционного
поля от центра к периферии дважды
(Йодонатом 1%, йодопирон 1%, гибитаном
0,5%, АХД)
обработать операционное поле после
отграничения стерильным бельём
обработать кожу перед наложением
швов
обработать кожу после наложения
швов
68.
Хирургическая дезинфекция рук• Обработка первомуром:
• Обработка хлоргексидином:
под проточной водой до локтя- 1мин.
• под проточной водой до локтя – 1 мин. высушивание стерильным полотенцем
высушивание стерильным полотенцем
двукратная обработка салфетками,
смоченными хлоргексидином 0,5%
обработка в тазу с раствором первомура
спиртовым
2,4% - 1 мин.
высушивание на воздухе
высушивание стерильным полотенцем
• Обработка АХД:
обработка под проточной водой 2 мин.
до локтя
просушивание стерильным полотенцем
обработка рук до локтя 5 мл АХД
высушивание на воздухе 2,5 мин.
обработка кистей рук 5мл АХД
высушивание на воздухе – 2,5мин.
Обработка церигелем
• на руки наносят 3 - 5 мл раствора
втирают в кожу в течение 10 сек.
пальцы чуть в согнутом состоянии, на
руках образуется плёнка. Перчатки
надевать не надо.
69.
Антисептика70.
Основатель антисептики ДжозефВЛистер
60-е гг. XIX века в Глазго
английский хирург Джозеф Листер,
ознакомленный с работами Луи
Пастера, предположил, что причина
нагноения ран – микробы, которые
попадают в рану из воздуха и с рук
хирурга и ввёл антисептический
метод борьбы с инфекцией. В 1865 г.
он, убедившись в антисептическом
действии карболовой кислоты,
применил повязку с ее раствором в
лечении открытого перелома и
распылил карболовую кислоту в
воздухе операционной.
71.
72.
73.
Антисептика – комплексмероприятий, направленных на:
Уничтожение или уменьшение
количества микробов в ране и в организме
Борьбу с интоксикацией
Повышение защитных сил организма
В России его развивали Субботин и Дьяконов
74.
Виды антисептикиМеханическая антисептика – ПХО раны
Физическая антисептика - гигроскопические
повязки; высушивание ран; дренирование, действие
света; сухого тепла; УФО; ультразвук
Химическая антисептика - применение препаратов
- антисептиков, обладающих бактерицидным и
бактериостатическим действием
Биологическая антисептика - методы воздействия
на биологический объект – пациент и биологические
патологические объекты – микроорганизмы (грибы,
простейшие, вирусы). Задача при воздействии на
макроорганизм – повысить его иммунитет, его
природные защитные силы. Задачей воздействия на
микроорганизмы – уничтожить их или хотя бы
ослабить их действие.
75.
Группы химических антисептиковГалоиды:
Настойка йода 5 -10 % (обработка кожи)
Йодопирон 0,5%-1%, йодонат 1% (обработка операционного поля)
Йодоформ 10% (мазь)
Хлорамин: дезинфекция рук (0,25 - 0,5%), обработка ран (1,5 - 2%),
дезинфекция помещение, предметов ухода, инструментов (1-3% раствор),
при туберкулёзе (3 - 5%)
Окислители:
калия перманганат 0,1% раствор – для полосканий горла промывание
желудка, спринцевания в урологии, гинекологии; 0,1 - 0,5% для промывания
ран; 2 - 5% – для прижигания язв, ожогов, пролежней
перекись водорода 3% – для промывания ран, для остановки кровотечения,
для предстерилизационной обработки; 6% – для дезинфекции и химической
стерилизации
пергидроль 27,5 - 33%
Кислоты:
борная 2% или в виде порошка для полоскания рта, зева, носоглотки,
промывания глаз, в виде порошка на раны
76.
Группы химических антисептиковЩёлочи: нашатырный спирт 10 % – при обмороках, 0,5% – обработка кожи
Спирты: этиловый спирт 70% – обработка кожи вокруг раны,
операционного поля, рук персонала, для химической стерилизации
инструментов; 96 % – обладает дубящим действием, при обработке рук
Красители:
бриллиантовый зелёный 1 - 2% спиртовой – обработка кожи, ран;
водный – обработка слизистых ротовой полости, гениталий, ран
метиленовый синий 1 - 3% спиртовой – обработка кожи
водный - обработка слизистых, промывания ран, мочевого пузыря, при
пиодермии, ожогах и т.д.; 0,2% раствор водный – при исследовании свищей
риванол 0,1- 0,2%
Соли тяжёлых металлов:
сулема 0,1% дезинфекция перчаток, оптики
нитрат серебра 1 - 2% (дезинфицирующее); 10-30% (прижигающее)
Альдегиды: формальдегид (табл.) – стерилизация аппаратуры, в
патанатомии
77.
Группы химических антисептиковДетергенты:
хлоргекседин (гибитан) 0,5% спиртового раствора - обработка
операционного поля, рук персонала; 0,05% раствор – промывание ран, ожогов,
слизистых оболочек; входит в состав АХД – специаль
церигель – сложный антисептик – обработка рук персонала (образует
плёнку)
Дегти, смолы: дёготь берёзовый – входит в мазь Вишневского (лечение ран)
Производные нитрофурана:
фурацилин 0,02 % водный – лечение ран, промывания полых органов, полостей
лифузоль – сложный антисептик, для лечения поверхностных, ран, для защиты
операционных ран, кожных швов (образуется плёнка)
Сульфаниламиды (бактериостатическое действие)
стрептоцид, этазол – для лечения ран в виде присыпок, в таблетках
бисептол – комбинированный препарат, длительного действия
Антисептики природного происхождения цветки календулы, листья
подорожника, крапивы (обработка ран, слизистых оболочек, кожи)
78.
Биологическая антисептикаК первой группе относят: переливание крови и её компонентов (гамма
глобулины, плазма), введение анатоксинов, проведение прививок.
Ко второй группе можно отнести применение антибиотиков, сывороток,
бактериофага, протеолитических ферментов.
Антибиотики – вещества микробного или синтетического происхождения,
действуют на патологические организмы, убивая их.
Бактериофаги – препараты, содержащие вирусы, которые, внедряясь в
микробную клетку, убивают её. Чаще всего используются
антистафилококовый и антистрептококовый бактериофаг. Применяют
местно для лечения гнойных ран и полостей.
Протеолитические ферменты – энзимотерапия, растворяя мёртвые
ткани, ферменты оказывают противовоспалительное действие, очищают
гнойные раны, язвы. Применяют энзимы местно, п/к, в/в, через ингаляции.
Получают энзимы: из поджелудочной железы животных (трипсин,
хемотрипсин), из бактерий (стрептокиназа и т.д.), из растений (папаин,
бромелаин)
Сыворотки – плазма крови без фибриногена, в которой в результате
иммунизации животного находятся выработанные антитела против
опасных инфекций.
79.
Осложнения при применении всехвидов антисептики
При механической антисептике возможно повреждение рядом и
нижележащих тканей и органов, например, сосудов. Возможно, неполное
удаление нежизненно способных тканей, инородных тел.
При химической антисептике возможны отравления, аллергические
реакции, дерматиты.
При физической антисептике возможно развитие фотодерматитов,
возникновение пролежней при длительном нахождении дренажа,
термические ожоги.
При биологической антисептике часто:
аллергические реакции,
диспепсические расстройства ЖКТ,
отравления от передозировки,
местная гиперемия кожи при введении анатоксина,
общая реакция на прививку,
токсическое воздействие на почки, печень, слуховой аппарат,
развитие кандидомикоза (развитие грибковых заболеваний, вызванных
применением антибиотиков),
дисбактериоза (нарушение микробного баланса в кишечнике с
преобладанием вредоносных форм).

Медицина
Медицина








